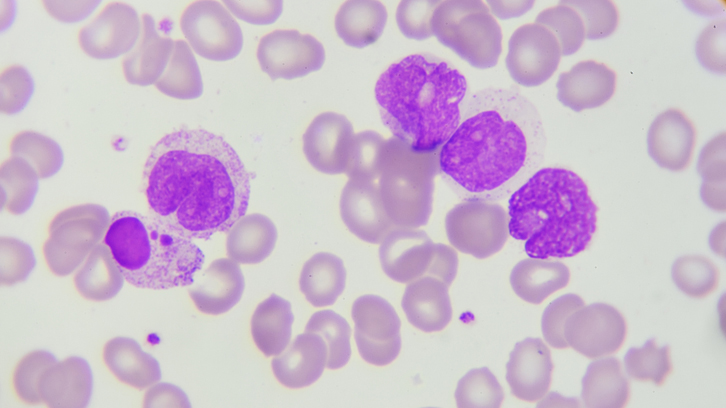
lenalidomida MTE

Estrès per calor, microbiota i barrera intestinal
L’estrès tèrmic pot afectar la salut i el benestar del ramat. Degut a la dificultat de portar un control exhaustiu del confort tèrmic de l’animal, s’ha realitzat un estudi per detectar i dilucidar els efectes de l’estrès...